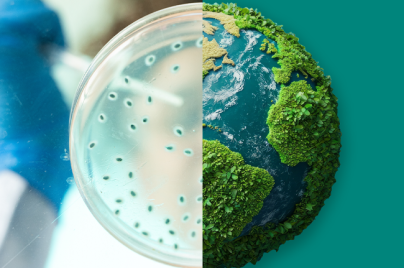

Helping lead the next wave in cancer care
Learn more

Patients
We’re here to help you get the information you need to guide you on your health journey.

Our culture and values
It all comes back to saving and improving lives.
Sustainability
We operate responsibly every day to enable a safe and healthy future for people and communities globally.

About us
For more than 130 years, we have brought hope to humanity through the development of important medicines and vaccines.

Our pipeline
We follow the science where we can make the greatest difference, now and in the future

Clinical trials
Clinical trials help find new treatments to help save and improve lives. Our progress is due in large part to the important and tough scientific questions we set out to answer with our trials and collaborations.